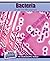
Bacteria Under the Microscope

Books by Simon Pierce

Simon Pierce
Average rating 3.63 · 75 ratings · 26 reviews · shelved 532 times
Average rating 3.63 · 75 ratings · 26 reviews · shelved 532 times
Showing 30 distinct works.
* Note: these are all the books on Goodreads for this author. To add more books, click here.